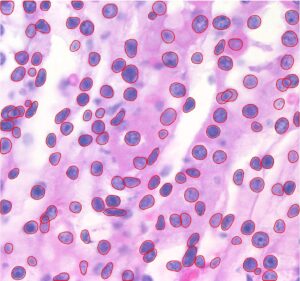
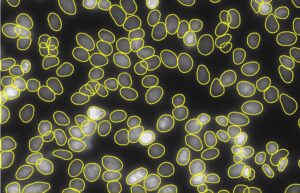

App Center
Discover solutions for specific image analysis challenges in our growing library. Covering various sample types, techniques, and modalities, our solutions can streamline your workflow development. Use the Industry and Application filters below to explore more options.
No apps found. Couldn't find what you were looking for? Connect with an imaging expert to learn how we can help.
- All
- Biomedical
- Cancer Research
- Cell Biology
- Histology/Pathology
- New
- Protocol-Guided
- AI-Powered
- All
- Area Fraction
- Ceramics & Polymers
- Coatings & Layers
- Electronics QA
- Grains
- Metallurgy
- Particles & Pores
- Textiles & Fibers
- New
- Protocol-Guided
- AI-Powered
Can’t find a solution for you?
Build your custom Image-Pro solution with an imaging expert.